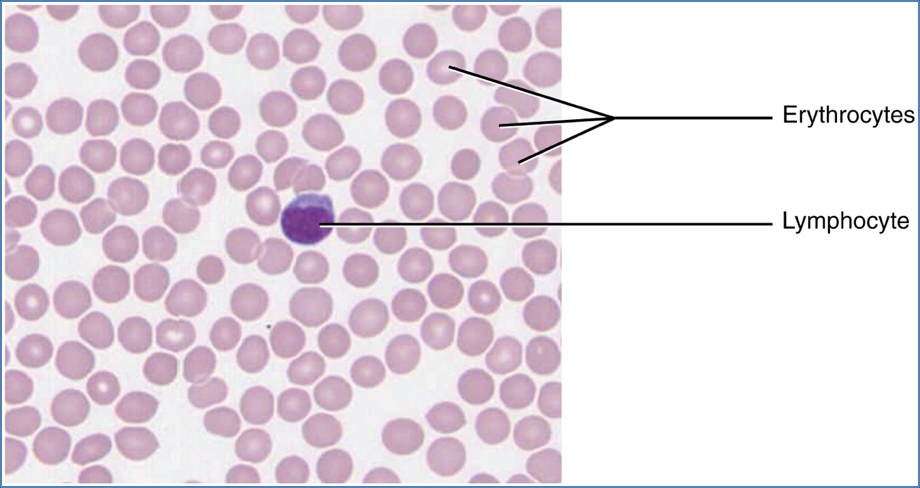
Blood

Table of Contents
Overview
Connective tissue is the most abundant and widely distributed of the four primary tissue types. It supports, binds, protects, and insulates body structures and transports substances. Found throughout the body, connective tissue ranges from rigid bone and cartilage to fluid blood and flexible adipose. This page explores the major classes, components, and histological features of connective tissue, all of which arise from embryonic mesenchyme and are unified by the presence of an extracellular matrix.

Definition
Connective tissue is a diverse group of tissues derived from mesenchyme that serve supportive, protective, metabolic, and transport functions. It consists primarily of a non-living extracellular matrix in which a variety of specialised cells are embedded.
Functions
- Binding and structural support
- Protection of internal organs
- Insulation (e.g. via adipose tissue)
- Transportation of gases, nutrients, and wastes (e.g. blood)
General Characteristics
- Common Origin: All connective tissues originate from embryonic mesenchyme.
- Vascularity:
- Cartilage → avascular
- Dense connective tissue → poorly vascular
- Most other types → richly vascularised
- Extracellular Matrix:
- Dominates tissue volume
- Provides strength and flexibility
- Allows connective tissues to endure mechanical stress

Structural Components
Ground Substance
- Unstructured interstitial fluid
- Cell adhesion proteins (laminin, fibronectin)
- Proteoglycans (trap water → determines matrix viscosity)
- Functions as a medium for nutrient and waste exchange between blood and cells
Fibres
- Collagen fibres (white fibres)
- Made of collagen protein
- Arranged in cross-linked fibrils
- High tensile strength and structural integrity
- Elastic fibres
- Long, thin, branching fibres made of elastin
- Allow stretch and recoil (present in skin, lungs, blood vessels)
- Reticular fibres
- Short, collagen-like fibres forming delicate networks
- Support soft tissues and blood vessels
- Prominent in basement membranes and lymphoid organs
Cells
- Immature (blast) cells: actively secrete matrix
- Fibroblasts → connective tissue proper
- Chondroblasts → cartilage
- Osteoblasts → bone
- Hematopoietic stem cells → blood
- Mature (cyte) cells: maintain the matrix
- E.g. chondrocytes, osteocytes
- Other cells:
- White blood cells, plasma cells
- Macrophages and mast cells → immune surveillance

Types of Connective Tissue

1. Connective Tissue Proper
Loose Connective Tissue
- Areolar
- Gel-like matrix with all three fibre types
- Contains fibroblasts, macrophages, mast cells, and white blood cells
- Most widely distributed connective tissue

- Adipose
- Adipocytes make up 90% of tissue mass
- Stores nutrients, insulates, cushions
- Located under the skin, around kidneys, and in breasts
- Rich blood supply

- Reticular
- Contains only reticular fibres
- Forms soft internal skeleton (stroma)
- Supports lymphoid organs (lymph nodes, spleen, bone marrow)

Dense Connective Tissue
- Dense Regular
- Parallel collagen fibres with few elastic fibres
- High tensile strength along one axis
- Forms tendons, ligaments, and fascia
- Contains fibroblasts
- Poorly vascularised
- Dense Irregular
- Thicker, irregularly arranged collagen bundles
- Withstands tension from multiple directions
- Found in dermis, fibrous joint capsules, coverings of kidneys, bones, muscles, and nerves

2. Cartilage
- Avascular and lacks innervation
- Matrix is ~80% water
- Surrounded by perichondrium (vascular connective tissue layer)
Hyaline Cartilage
- Most abundant cartilage type
- Matrix with firmly bound collagen fibres
- Found in: embryonic skeleton, ribs, nose, trachea, larynx, synovial joints
Elastic Cartilage
- Like hyaline but with more elastin
- Provides flexibility and shape retention
- Found in external ear and epiglottis
Fibrocartilage
- Combines strength of dense connective tissue with compressibility of cartilage
- Found in intervertebral discs, pubic symphysis, and menisci

3. Bone (Osseous Tissue)
- Hard, calcified matrix with abundant collagen
- Osteoblasts produce matrix; osteocytes maintain it
- Highly vascularized
- Contains osteons (concentric lamellae with central canals)
- Functions: Support, protection, mineral storage, blood cell production

4. Blood
- Atypical connective tissue
- Consists of red and white blood cells suspended in plasma
- Matrix = non-living fluid (plasma)
- Develops from mesenchyme
- Transports gases, nutrients, hormones, and wastes
- Confined to blood vessels
Summary
Connective tissue supports and integrates the body’s tissues and organs, ranging from fluid plasma in blood to the rigidity of bone. All types share a mesenchymal origin and contain a rich extracellular matrix, allowing for resistance to mechanical stress. The four classes—connective tissue proper, cartilage, bone, and blood—serve essential roles in structural support, protection, and nutrient transport. For further foundational study, see our Cell Biology & Biochemistry Overview page.